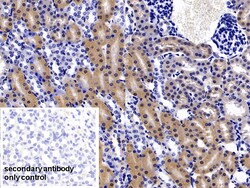
Invitrogen FABP1 Polyclonal Antibody, Invitrogen 20 &mu;L; Unconjugated:Anticuerpos

missing translation for 'onlineSavingsMsg'
Learn More
Learn More
Invitrogen™ FABP1 Polyclonal Antibody, Invitrogen™
Rabbit Polyclonal Antibody
Marca: Invitrogen™ PA5145248
Este artículo no se puede devolver.
Vea la política de devoluciones
Descripción
FABP1 encodes the fatty acid binding protein found in liver. Fatty acid binding proteins are a family of small, highly conserved, cytoplasmic proteins that bind long-chain fatty acids and other hydrophobic ligands. FABP1 and FABP6 (the ileal fatty acid binding protein) are also able to bind bile acids. It is thought that FABPs roles include fatty acid uptake, transport, and metabolism.
Especificaciones
| FABP1 | |
| Polyclonal | |
| Unconjugated | |
| FABP1 | |
| 14 kDa selenium-binding protein; FABP1; FABPL; Fabplg; fatty acid binding protein 1; fatty acid binding protein 1, liver; fatty acid binding protein liver; fatty acid-binding protein 1; Fatty acid-binding protein, liver; L-FABP; Liver-type fatty acid-binding protein; p14; SCP; SCP.; Squalene- and sterol-carrier protein; Z-protein | |
| Rabbit | |
| Antigen affinity chromatography, Protein A | |
| RUO | |
| 14080, 2168, 24360, 445535 | |
| Store at 4°C short term. For long term storage, store at -20°C, avoiding freeze/thaw cycles. | |
| Liquid |
| Immunohistochemistry (Paraffin), Western Blot | |
| 0.5 mg/mL | |
| PBS with 50% glycerol and 0.05% Proclin 300; pH 7.4 | |
| P02692, P07148, P12710, P49924 | |
| FABP1 | |
| Recombinant Human FABP1 protein, Ser2-Ile127 (Accession #P07148). | |
| 20 μL | |
| Primary | |
| Human, Mouse, Rat, Pig | |
| Antibody | |
| IgG |
Título del producto
Al hacer clic en Enviar, acepta que Fisher Scientific se ponga en contacto con usted en relación con los comentarios que ha proporcionado en este formulario. No compartiremos su información para ningún otro fin. Toda la información de contacto proporcionada se mantendrá de acuerdo con nuestra Política de Privacidad. Política de privacidad.
¿Detecta una oportunidad de mejora?